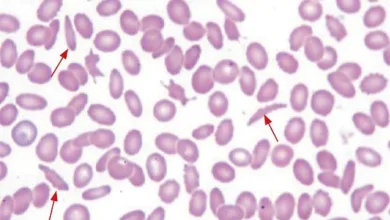

Hospital Nacional de Niños
-
Salud

La unidad de quemados de Costa Rica, una luz de esperanza para los niños costarricenses
Doña Clemencia preparaba donas para su hijo Felipe y sus amigos. En un descuido, Felipe tomó la olla de aceite…
Leer más » -
Salud

Reportaje: Anemias en Costa Rica, una realidad poco conocida
El Centro de Investigación en Hematología y Trastornos Afines (CIHATA) de la Universidad de Costa Rica se encuentra realizando un…
Leer más » -
Salud

Campaña de donación: La Posada del Alivio busca $1.5 millones para su reconstrucción
La Posada del Alivio, un albergue vital para las familias de niños internados en el Hospital Nacional de Niños, ha…
Leer más » -
Salud

Hospital Nacional de Niños, 61 años de Servicio
El Hospital Nacional de Niños surge de la visión del médico pediatra Dr. Carlos Luis Sáenz Herrera y se hizo…
Leer más » -
Nacionales

BCIE impulsa Torre de Cuidados Críticos para Niños en Costa Rica
La Torre de Cuidados Críticos del Hospital Nacional de Niños Dr. Carlos Sáenz Herrera será una realidad tras esperar dos…
Leer más » -
Salud

Convenio entre CCSS y Heart to Heart impulsa la salud cardiovascular en Costa Rica
Por: Fabricio Alfredo Obando Chan, periodista. La Caja Costarricense del Seguro Social y la fundación Heart to Heart se unen…
Leer más » -
Salud

Más de 1500 pacientes diagnosticados con enfermedades raras por la CCSS
Por: Fabricio Alfredo Obando Chan, periodista. Cada 28 de febrero se celebra el Día de las Enfermedades Raras con la…
Leer más » -
Nacionales

CCSS reconoce labor de las Unidades de Quemados
Por: Fabricio Alfredo Obando Chan, periodista de Puntarenas Se Oye. Juan es un químico y trabajador en una empresa…
Leer más » -
Salud

Hospital de Niños pide reforzar medidas sanitarias para prevenir y cortar trasmisión de virus respiratorios
El hospital Nacional de Niños mantiene una alta ocupación de niños hospitalizados por enfermedades respiratorias. Los virus que más están…
Leer más »